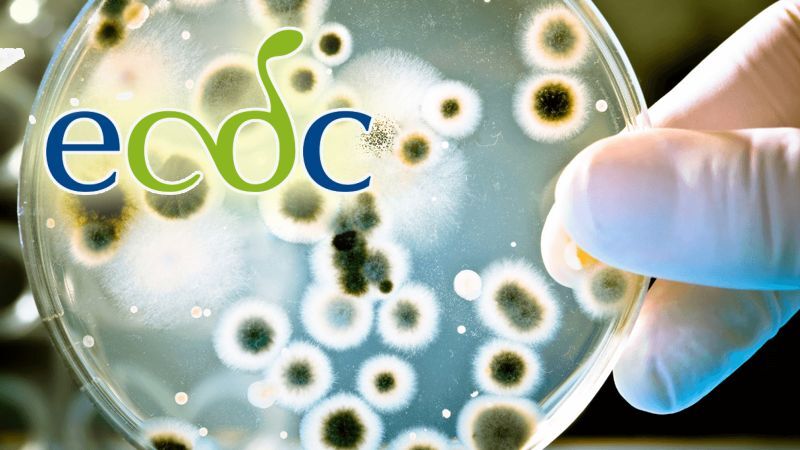

Hvordan kan EU vende den negative udvikling med antimikrobiel resistens?
Skrevet af Torben Wilkenschildt, ons, 19/11/2025 - 06:21
Sundhed & sygdom | AMIGOS
INDSIGT: Den manglende mulighed for behandling af et stigende antal patienter bekymrer centret for forebyggelse.
I går, hvor Europa markerer den europæiske antibiotikadag, afslører nye data offentliggjort af Det Europæiske Center for Forebyggelse af og Kontrol med Sygdomme (ECDC), en barsk virkelighed: antimikrobiel resistens (AMR) fortsætter med at stige i hele Den Europæiske Union og Det Europæiske Økonomiske Samarbejdsområde (EU/EØS) og truer med at vende årelange medicinske fremskridt.
Hvad er antimikrobiel resistens?
Kan måske også interessere dig
Påskeæggene er reddet!
Spanien ophæver restriktioner mod fugleinfluenza lige før påske
Få penge for at flytte på landet: Her er støtten til boligkøb i det ″tømte″ Spanien
Læs om de støttemuligheder, der findes for de yngre, som overvejer at bytte storbyens larm ud med roen i de spanske landsbyer.
Kystperlen over dem alle i Catalonien
Charmerende fiskerby i Nordspanien.
Kommentarer
COPYRIGHT: Det er ikke tilladt at kopiere hverken helt eller delvist fra Spanien i dag uden aftale.









.jpg)








